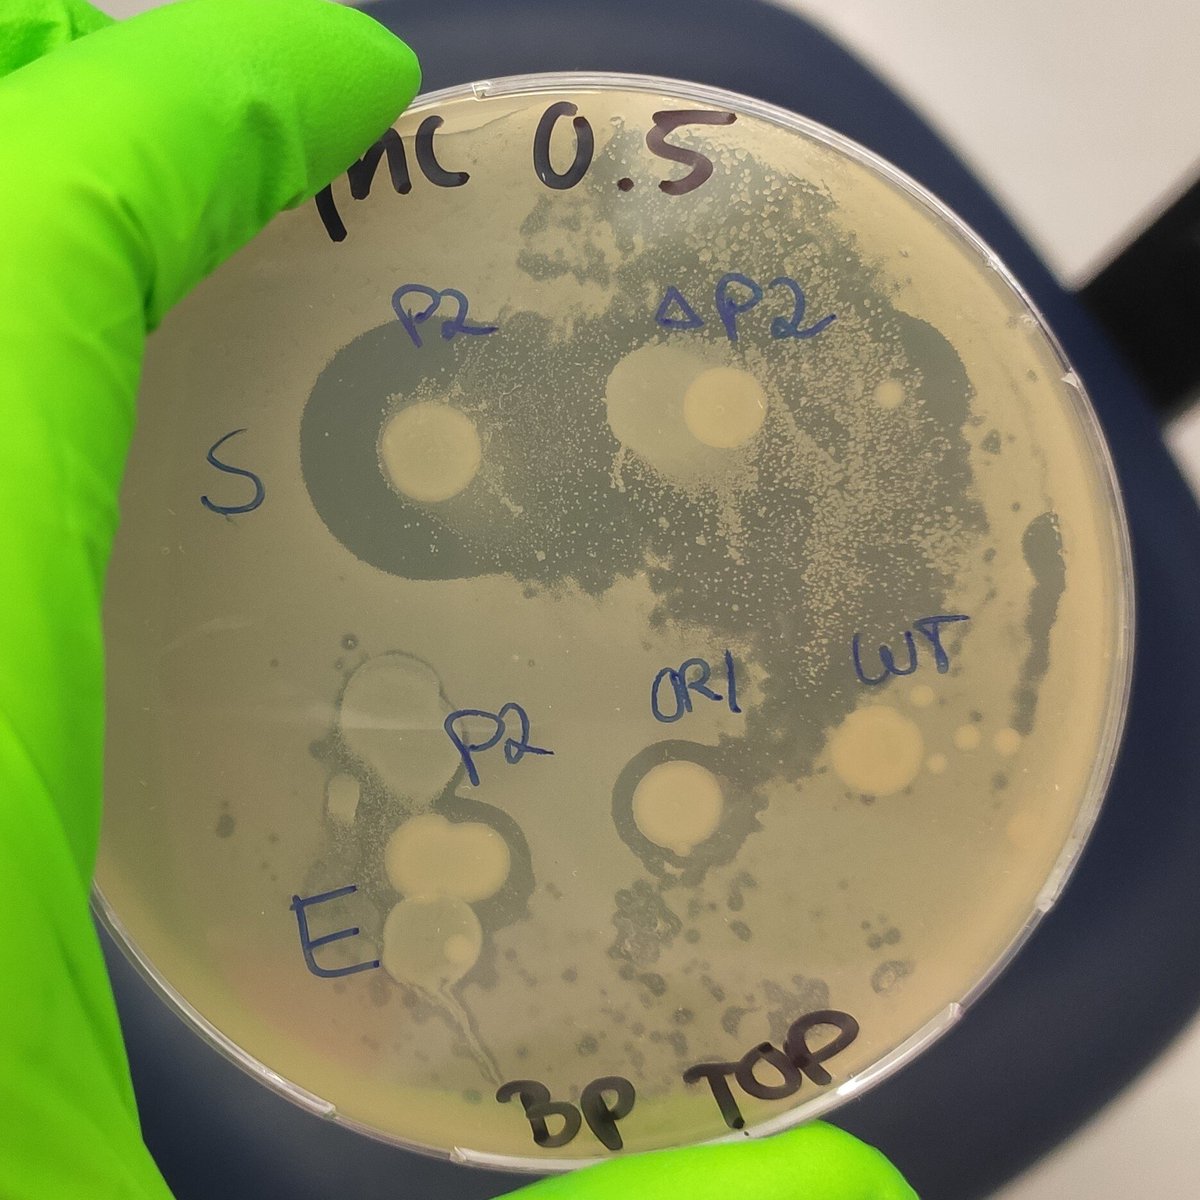
Prokaryota's tweet image. In an effort to provide a more realistic perspective on empirical research, here&apos;s my ugly ass overlay assay  #labreality #hotmess

#labreality Suchergebnisse
In an effort to provide a more realistic perspective on empirical research, here's my ugly ass overlay assay #labreality #hotmess

What’s harder than LIMS implementation? Getting everyone to use it the same way. We build SOP-aligned systems that match how your lab actually works. #LIMSHumor #LabReality
Loved this! #labreality
During weekly lab meetings the people in my group present in one slide the highlights/progress of the past week. This is the best slide we’ve ever had. We laughed so much and hugged because: science is hard, it’s okay to admit it, and we are all in it together 🙂#mentalhealth

What’s harder than LIMS implementation? Getting everyone to use it the same way. We build SOP-aligned systems that match how your lab actually works. #LIMSHumor #LabReality
Loved this! #labreality
During weekly lab meetings the people in my group present in one slide the highlights/progress of the past week. This is the best slide we’ve ever had. We laughed so much and hugged because: science is hard, it’s okay to admit it, and we are all in it together 🙂#mentalhealth

In an effort to provide a more realistic perspective on empirical research, here's my ugly ass overlay assay #labreality #hotmess

In an effort to provide a more realistic perspective on empirical research, here's my ugly ass overlay assay #labreality #hotmess
Something went wrong.
Something went wrong.
United States Trends
- 1. National Guard 103K posts
- 2. Thanksgiving 426K posts
- 3. #InfoSecVPN N/A
- 4. Frank Ragnow 4,077 posts
- 5. D.C. 219K posts
- 6. Mbappe 90.1K posts
- 7. Bayern 164K posts
- 8. Arsenal 292K posts
- 9. Patrick Morrisey 2,099 posts
- 10. Kimmich 5,558 posts
- 11. Merino 8,088 posts
- 12. Denzel 4,315 posts
- 13. Olympiacos 21.1K posts
- 14. Lennart Karl 6,402 posts
- 15. Anthony Rendon N/A
- 16. WV Governor 2,205 posts
- 17. Golesh 3,228 posts
- 18. Wine 40.2K posts
- 19. Vini 33.2K posts
- 20. Pizza 47.9K posts





